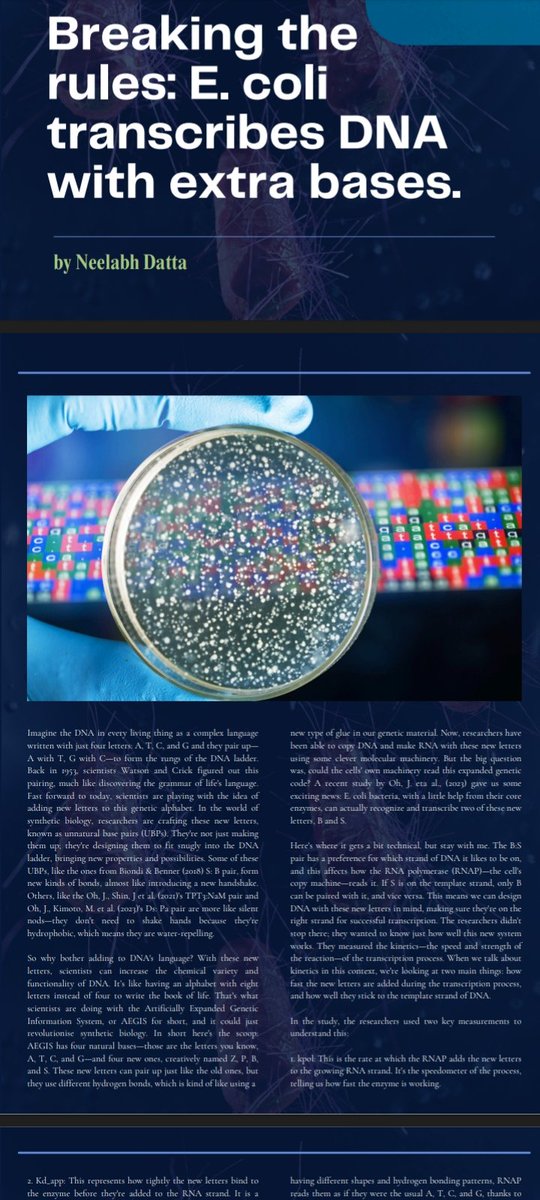
Neelabh Datta tweet media

Exhibit A retweetledi

Get ready for Ishya ‘25, whence the magic in the air and which flows through our veins brings to life a celebration of ethereal talent, boundless enthusiasm, and joyful dreams. This Ishya will be a divine experience that borders on the supernatural—embrace its magic!
#Ishya25

English